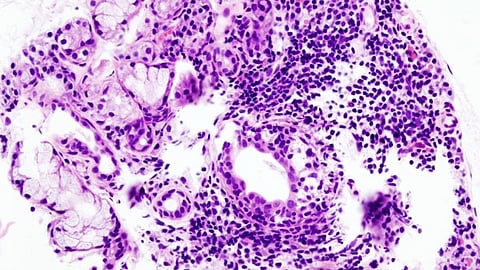

A new study from researchers at Regenstrief Institute and Indiana University School of Dentistry reports on linking electronic health records and electronic dental records to provide better care and outcomes for individuals with Sjogren's disease, an autoimmune disorder that can affect the entire body, including teeth. Their work may have implications for other systemic autoimmune diseases, including lupus and possibly rheumatoid arthritis.
Sjogren’s is a chronic autoimmune connective tissue disorder affecting four million Americans plus an unknown number who are undiagnosed. Patients with this condition may also have other autoimmune disorders.
Historically, because of the separation of dental and medical care, electronic medical and dental records are not linked or routinely shared. Dental providers rely on patients to report their diagnosis of Sjogren's as this information is not conveyed by their physicians. As a result, dentists typically recognize the patient’s condition late in the disease process when tooth decay leading to significant tooth loss is manifested.
The Regenstrief and IU researchers linked electronic health records from the Indiana Network for Patient Care of individuals with Sjogren's disease with their electronic dental records. Fewer than a third of patients diagnosed by their physicians had informed their dental providers of the diagnosis. Without this information, dentists didn’t know to provide treatment which could help preserve teeth and improve overall health.
This is one of the first studies to characterize how physicians diagnose Sjogren's in community practice settings and to illustrate different clinical presentations of the disease using matched electronic dental and health records.
Sjogren's is difficult to diagnose because it has many symptoms which are similar to those of other conditions and there is no single, definitive test for Sjogren's. The most common symptoms include dryness of the mouth and eyes, tooth decay, fatigue and chronic pain. But major organ involvement, neuropathies and lymphomas may also occur.
In the United States, the average time from onset of symptoms to diagnosis is three years, allowing the disease to initially progress unchecked. Nine out of 10 individuals with Sjogren's are women.
In spite of the fact that patients with Sjögren's disease typically have a high level of awareness regarding their health, because they don’t inform their dentist, they end up losing their teeth, which can have a huge impact on their quality of life. They may be unable to hold full-time jobs because they have a lot of dental decay and have missing or damaged teeth. Without the information from the patient’s electronic medical record, dentists don’t have a complete picture and don’t know to evaluate treatment which could preserve teeth.
“This is a goal we hope to facilitate by showing the benefits of linking electronic dental and medical records. Unfortunately, Medicare and many health insurances do not pay for tests and treatments performed in dental offices, which makes working together with physicians more difficult for oral health providers. Screening and awareness of Sjogren's and its symptoms should be spread through educational programs targeting women to encourage them to talk to both medical and dental clinicians.” (VKR/Newswise)